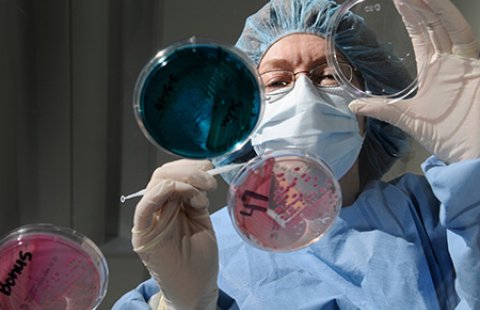

Led by the College of Sciences, in January 2022 ODU earned Research 1 status from the Carnegie Classification of Institutions of Higher Education. This places the university among an elite group of research institutions in the nation designated by "very high research activity" and reflects its continued growth.
The Carnegie Classification®, which has been the leading measure of research activities at U.S. colleges and institutions for more than half a century, means ODU joins the top 5% of four-year research institutions in the U.S.
To achieve R1 status, universities must meet benchmarks across 10 indicators, including research doctorates awarded, total research grants and expenditures, scholarly publications, and number of Ph.D. research staff, all of which continues to grow in the College of Sciences, and the University at large.
Departmental Research
Research Centers & Computation Facilities
In departmental research labs, research centers and in the field, our faculty investigate important scientific questions ranging from the workings of the atomic nucleus to the environmental quality of the Chesapeake Bay.